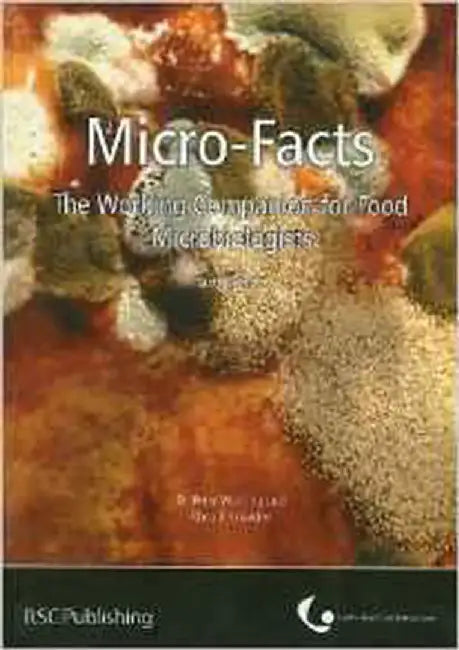
Micro-Facts: The Working Companion for Food Microbiologists by Peter Wareing

Food Science & Technology
Filters
- Agro-Bios (1)
- Alpha Edition (1)
- Anness Publishing (1)
- Apple Press (1)
- Arcadia Publishing Library Editions (1)
- Astral International (1)
- Atlantic Publishers & Distributors (P) Ltd (4)
- Benediction Classics (1)
- Birlinn General (1)
- Bloomsbury (3)
- Bloomsbury Publishing PLC (1)
- Bookmagic, LLC (1)
- Bristol Publishing Enterprises (1)
- CABI (13)
- Cambridge UP (1)
- Columbia UP (1)
- Countryman Press (1)
- CRC Press (3)
- Createspace (1)
- Createspace Independent Publishing Platform (11)
- Delve Publishing (1)
- Dorling Kindersley Ltd (1)
- Elsevier (72)
- Fox Chapel Publishers International (1)
- Francis Michael Publishing Company (1)
- Hassell Street Press (1)
- Headline Publishing Group (1)
- IGI Global (1)
- Independently Published (6)
- International Labour Office (1)
- Ishwar Books (1)
- iUniverse (1)
- Kalyani (1)
- Leatherhead Food (3)
- Little Brown (1)
- Long Barn (1)
- Lulu.com (2)
- Mapin Publishing (1)
- Marlowe & Company (1)
- Medtec (2)
- MEDTEC (1)
- Narendra Publishing (1)
- New Harbinger Publications (1)
- Niyogi Books (1)
- Northern House Media LLC (1)
- Other Publications (2)
- Oxford University Press (1)
- Oxford University Press, USA (1)
- Oxford UP (9)
- Parragon Publishing (1)
- Pearson (1)
- Pluto (2)
- Pluto Press (1)
- Pluto Press (UK) (1)
- Practical Action Pub (1)
- Pub Overstock (1)
- Publications International (1)
- Ratna Sagar (1)
- ReadHowYouWant (1)
- Rockridge Press (2)
- Routledge (1)
- Royal Society of Che (14)
- Royal Society of Chemistry (1)
- Sage Publications (1)
- Search Press (1)
- Snab Publishers (1)
- Speedy Title Management LLC (2)
- Springer (1)
- Springer Verlag (21)
- Sproutman Publications (1)
- T&F (62)
- Taylor & Francis (4)
- Taylor & Francis Group (5)
- Tortillaville (1)
- Tulika Books (1)
- Wageningen Academic (4)
- Webster's Digital Services (1)
- Wiley (75)
- wiley (1)
- Wiley india Pvt. Ltd (1)
- Woodhead (6)
- Acad Pr (62)
- Agro-Bios (1)
- Alpha Edition (1)
- Anness Publishing (1)
- Apple Acad (1)
- Apple Pres (1)
- Arcadia Publishing Library Editions (1)
- Astral International (1)
- Atlantic (4)
- Benediction Classics (1)
- Birlinn General (1)
- Blackwell (1)
- Bloomsbury (2)
- Bloomsbury Academic (1)
- Bloomsbury Publishing PLC (1)
- Bookmagic, LLC (1)
- Bristol Publishing Enterprises (1)
- CABI (10)
- CABI Publishing (3)
- Cambridge (1)
- Chapman Hall (2)
- ColumbiaUP (1)
- Countryman Press (1)
- CRC Press (52)
- Createspace (1)
- Createspace Independent Publishing Platform (11)
- Delve Publishing (1)
- Dorling Kindersley Ltd (1)
- Dreamtech Press (1)
- Dummies (1)
- Elsevier (4)
- Fox Chapel Publishers International (1)
- Francis Michael Publishing Company (1)
- Hassell Street Press (1)
- Headline Pub. (1)
- IGI Global (1)
- Independently Published (6)
- International Labour Office (1)
- Ishwar Books (1)
- iUniverse (1)
- John Wiley (7)
- Kalyani (1)
- Leatherhd. (3)
- Little Brown (1)
- Long Barn (1)
- Lulu.com (2)
- MapinPub (1)
- Mar Dekker (5)
- Marlowe (1)
- Medtec (2)
- MEDTEC (1)
- Narendra Publishing (1)
- New Harbinger Publications (1)
- NiyogiBook (1)
- Northern House Media LLC (1)
- OtherPub (2)
- Oxford University Press, USA (1)
- Oxford UP (10)
- Parragon P (1)
- Pluto (2)
- Pluto Press (1)
- Pluto Press (UK) (1)
- Polity Pr (1)
- Practical (1)
- Prent Hall (1)
- PrimusBook (1)
- Pub Overst (1)
- Publications International (1)
- ReadHowYouWant (1)
- Rockridge Press (2)
- Routledge (8)
- Royal Society of Chemistry (1)
- RSC (14)
- SAGE India (1)
- Search Press (1)
- Snab Publishers (1)
- Speedy Title Management LLC (2)
- Springer (22)
- Sproutman Publications (1)
- Taylor & Francis (2)
- Tortillaville (1)
- Tulika Books (1)
- Wageningen (4)
- Webster's Digi.Serv. (1)
- Wiley (27)
- wiley (1)
- Wiley india Pvt. Ltd (1)
- Wiley-Blac (30)
- Wiley-ISTE (3)
- Wiley-Scri (1)
- Woodhead (12)
- A. Smith (1)
- A.Y. Tamime (1)
- Accorsi Riccardo (1)
- Achaya K T (1)
- Ahire (1)
- Ahmed (1)
- Al Meyer (1)
- Alan L. Kelly (1)
- Alan McHughen (1)
- Alasalvar (1)
- Alberto Escarpa (1)
- Alexander Cartus (1)
- Alexandru Grumezescu (3)
- Alexandru Mihai Grumezescu (2)
- Alina Maria Holban (1)
- Allen, Stefanie (1)
- Alvord, Henry E. (1)
- Amitava Mukherjee (1)
- Amos Nussinovitch (1)
- Anandharamakrishnan (1)
- Anas M. Abdel Rahman (1)
- Andersen (1)
- Anderson de Souza Sant'Ana (1)
- Anderson Sant'Ana (1)
- Andree Voilley (1)
- Andres Illanes (1)
- Andrew Gordon (1)
- Andy Rathbone (1)
- Andy Rees (1)
- Ann-Charlotte Eliasson (1)
- Anthony L. Pometto III (1)
- Anton J. Haverkort (1)
- Antonio Lopez- Gomez (1)
- Antony (1)
- Aron, Jules (1)
- Ashley John (1)
- Augusto (1)
- Axel Rossberg (1)
- Azor Thurston (1)
- B. Dave Oomah (1)
- B. K. Bala (1)
- Bai, Jamuna A (1)
- Bamforth (1)
- Barba (1)
- Barbara Speranza (1)
- Basantia (1)
- BASHIR (1)
- Basil Jarvis (1)
- Berry, C. J. J. (1)
- Bev Bennett (1)
- Biswas Debabrata (1)
- Bordiga (1)
- Brehm Randy (1)
- Brett Wills (1)
- Brian J. Branigan (1)
- Brian, Lisa (1)
- C. K. Sunil (1)
- Cachon Remy (1)
- Caraher (1)
- Cerqueira (1)
- Cesarettin Alasalvar (1)
- Charis Michel Galanakis (1)
- Charles J. Alaimo (1)
- Charlette Gallagher (1)
- Charlie Clutterbuck (1)
- Chelladurai (1)
- Chemat Farid (1)
- Cheryl J. Baldwin (1)
- Chi-Tang Ho (1)
- Christian Salles (1)
- Christine Boisrobert (1)
- Christine Williams (2)
- Clara Silvestre (1)
- Clark (1)
- Colm O'Donnell (1)
- Coveney (1)
- Damia Barcelo (1)
- Daniela SoleriDavid A. ClevelandSteven E. Smith (1)
- Darryl G. Black (1)
- Dash (1)
- David Evans (1)
- David Kilcast (1)
- DIONISI (1)
- DK (1)
- Galanakis Charis (5)
- Gary Reineccius (2)
- Geoff Andrews (2)
- Grumezescu Alexandru (2)
- Jeffrey P. Miller (2)
- John Coveney (2)
- Mark Gibson (2)
- Pang Guo-Fang (2)
- Rhea Ferandes (3)
- Romain Jeantet (2)
- S.C. Bhatia (4)
- Steven Ricke (2)
- Victor R. Preedy (2)
- Victoria Emerton (2)
- Y.H. Hui (3)
- Zollo Stephen (4)
The Slow Food Story: Politics and Pleasure
Geoff Andrews
Paperback
• Author(s): Geoff Andrews • Publisher: Pluto • Publisher Imprint: Pluto • Subject: Food Science & Technology • BISAC: NGOs (Non-Governmental Organizations)About the Book The Slow Food movement was set up in Italy as a response to the dominan...
View full detailsThe Chemistry Of Cereal Proteins
Radomir Lasztity
Hardcover
• Author(s): Radomir Lasztity • Publisher: Taylor & Francis • Publisher Imprint: CRC Press • Subject: Food Science & Technology • BISAC: Food Science - GeneralAbout the Book In the past decade, since the first edition was published, the s...
View full detailsTaste Vs. Fat: How to Save Money, Time, and Your Taste Buds
Elaine Magee
Paperback
• Author(s): Elaine Magee • Publisher: Wiley • Publisher Imprint: Wiley • Subject: Food Science & TechnologyAbout the Book Your guide to the best of the "lights." Finding low-fat and fat-free brand-name foods that taste good doesn't have to b...
View full detailsStatistical Process Control For The Food Industry: A Guide For Practitioners And Managers
Antony
Hardcover
• Author(s): Antony • Publisher: Wiley • Publisher Imprint: Blackwell • Subject: Food Science & Technology • BISAC: Operations ResearchAbout the Book A comprehensive treatment for implementing Statistical Process Control (SPC) in the food ind...
View full detailsStatistical Aspects Of The Microbiologic
Basil Jarvis
Hardcover
• Author(s): Basil Jarvis • Publisher: Elsevier • Publisher Imprint: Acad Pr • Subject: Food Science & Technology • BISAC: Food ScienceAbout the Book For many biologists, statistics are an anathema; but statistical analysis of quantitative an...
View full detailsSalt: Grain of Life
Pierre Laszlo
Hardcover
• Author(s): Pierre Laszlo • Publisher: Columbia UP • Publisher Imprint: ColumbiaUP • Subject: Food Science & Technology • BISAC: Specific Ingredients - Herbs, Spices, CondimentsAbout the Book For the sake of salt, Rome created a system of re...
View full detailsPurposely Profitable: Embedding Sustainability into the DNA of Food Processing and Other Businesses
Brett Wills
Paperback
• Author(s): Brett Wills • Publisher: Wiley • Publisher Imprint: Blackwell • Subject: Food Science & Technology • BISAC: Food Science - GeneralAbout the Book Competing and winning in today�s competitive marketplace requires a strategy that in...
View full detailsPrinciples of Food Sanitation
Marriott
Paperback
• Author(s): Marriott • Publisher: Springer Verlag • Publisher Imprint: Springer • Subject: Food Science & Technology • BISAC: Food Science - Chemistry & BiotechnologyAbout the Book Now in its 6th Edition, this highly acclaimed textbook p...
View full detailsPhysical Properties Of Foods: Novel Measurement Techniques and Applications
Ignacio Arana
Hardcover
• Author(s): Ignacio Arana • Publisher: Taylor & Francis • Publisher Imprint: CRC Press • Subject: Food Science & Technology • BISAC: Food Science - GeneralAbout the Book With higher food quality in increasing demand by consumers, there i...
View full detailsNanoscience and Nanotechnology in Foods and Beverages
Chelladurai
Hardcover
• Author(s): Chelladurai • Publisher: Taylor & Francis • Publisher Imprint: CRC Press • Subject: Food Science & Technology • BISAC: Food Science - GeneralAbout the Book Potential applications of nanotechnology in food industry include: en...
View full detailsMicro-Facts: The Working Companion for Food Microbiologists
Peter Wareing
Paperback
• Author(s): Peter Wareing • Publisher: Royal Society of Che • Publisher Imprint: RSC • Subject: Food Science & TechnologyAbout the Book Micro-Facts has proved to be a useful ready reference for practising food microbiologists and others conc...
View full detailsMicrobiology Handbook: Meat Products
Rhea Ferandes
Hardcover
• Author(s): Rhea Ferandes • Publisher: Leatherhead Food • Publisher Imprint: Leatherhd. • Subject: Food Science & TechnologyAnimal flesh consumed as food is labelled 'meat'; it refers mainly to skeletal muscle and associated fat, but it may ...
View full detailsMicrobiology Handbook - Fish And Seafood
Rhea Ferandes
Hardcover
• Author(s): Rhea Ferandes • Publisher: Leatherhead Food • Publisher Imprint: Leatherhd. • Subject: Food Science & Technology • BISAC: Food ScienceFish and seafood are prime sources of animal protein. Because of their health advantages over r...
View full detailsMagnetic Resonance In Food Science: From Food to Thought
John van Duynhoven, Peter S. Belton, G.A. Webb
Hardcover
• Author(s): John van Duynhoven | Peter S. Belton | G.A. Webb • Publisher: Royal Society of Che • Publisher Imprint: RSC • Subject: Food Science & Technology • BISAC: Food Science - GeneralAbout the Book Based on the proceedings of the 11th I...
View full detailsMagnetic Resonance In Food Science: Challenges in a Changing World
Maria Gudjonsdottir, P. S. Belton, G.A. Webb
Hardcover
• Author(s): Maria Gudjonsdottir | P. S. Belton | G.A. Webb • Publisher: Royal Society of Che • Publisher Imprint: RSC • Subject: Food Science & Technology • BISAC: Food Science - GeneralAbout the Book With contributions from international ex...
View full detailsImproving Seafood Products For The Consumer
Torger Borresen
Hardcover
• Author(s): Torger Borresen • Publisher: Woodhead • Publisher Imprint: Woodhead • Subject: Food Science & Technology • BISAC: Food ScienceAbout the Book It is widely accepted that increased consumption of seafood is important in dealing with...
View full detailsHandbook Of Sustainability For The Food Sciences
Ruben O. Morawicki
Hardcover
• Author(s): Ruben O. Morawicki • Publisher: Wiley • Publisher Imprint: Wiley-Blac • Subject: Food Science & Technology • BISAC: Food Science - GeneralMany books on sustainability have been written in the last decade, most of them dealing wit...
View full detailsHandbook Of Mineral Elements In Food
Miguel de la Guardia, Salvador Garrigues
Hardcover
• Author(s): Miguel de la Guardia | Salvador Garrigues • Publisher: Wiley • Publisher Imprint: Blackwell • Subject: Food Science & Technology • BISAC: Diet & Nutrition - DietsMineral elements are found in foods and drink of all different ...
View full detailsHandbook Of Dietary Fiber: An Applied Approach
M.L. Dreher
Hardcover
• Author(s): M.L. Dreher • Publisher: Taylor & Francis • Publisher Imprint: CRC Press • Subject: Food Science & Technology
Handbook of Cereals Pulses Roots and Tubers
Zollo, Stephen
Hardcover
• Author(s): Zollo | Stephen • Publisher: Taylor & Francis • Publisher Imprint: CRC Press • Subject: Food Science & Technology • BISAC: Food Science - GeneralAbout the Book Cereals, pulses, roots, and tubers are major food sources worldwi...
View full detailsGums And Stabilisers For The Food Industry 14
Peter A. Williams, Glyn O. Phillips
Hardcover
• Author(s): Peter A. Williams | Glyn O. Phillips • Publisher: Royal Society of Che • Publisher Imprint: RSC • Subject: Food Science & Technology • BISAC: Food Science - GeneralAbout the Book A useful information source for researchers and ot...
View full detailsGoing Organic: Mobilising Networks for Environmentally Responsible Food Production
S. Lockie, Others
Hardcover
• Author(s): S. Lockie | Others • Publisher: CABI • Publisher Imprint: CABI • Subject: Food Science & Technology • BISAC: Agriculture - Sustainable AgricultureAbout the Book This book sets out to examine what really is going on in the organic...
View full detailsGM Agriculture and Food Security: Fears and Facts
Stuart SmythWilliam A KerrPeter W B Phillips
Paperback
• Author(s): Stuart SmythWilliam A KerrPeter W B Phillips • Publisher: CABI • Publisher Imprint: CABI • Subject: Food Science & Technology • BISAC: Agriculture - Agronomy - Crop ScienceAbout the Book Efforts to improve food security in the de...
View full detailsGlobalization of Indian Food
Shobha Kumari
Hardcover
• Author(s): Shobha Kumari • Publisher: Ishwar Books • Publisher Imprint: Ishwar Books • Subject: Food Science & Technology
Foodborne Disease Handbook: Viruses, Parasites, Pathogens and HACCP (Vol. 2)
Y. H. Hui, Others
Hardcover
• Author(s): Y. H. Hui | Others • Publisher: Taylor & Francis • Publisher Imprint: CRC Press • Subject: Food Science & TechnologyAbout the Book A study of foodborne disease, focusing on viruses, parasites, pathogens and HACCP. This second...
View full detailsFoodborne Disease Handbook: Seafood and Environmental Toxins (Vol. 4)
Y.H. Hui, David Kitts
Hardcover
• Author(s): Y.H. Hui | David Kitts • Publisher: Taylor & Francis • Publisher Imprint: CRC Press • Subject: Food Science & TechnologyAbout the Book A study of foodborne disease, focusing on seafood and environmental toxins. This second ed...
View full detailsFoodborne Disease Handbook: Plant Toxicants (Vol. 3)
Y.H. Hui, Roy Smith
Hardcover
• Author(s): Y.H. Hui | Roy Smith • Publisher: Taylor & Francis • Publisher Imprint: CRC Press • Subject: Food Science & TechnologyAbout the Book A study of foodborne disease, focusing on plant toxicants. This second edition contains new ...
View full detailsFoodborne Disease Handbook: Bacterial Pathogens (Vol. 1)
Y.H. Hui, Merle D. Pierson
Hardcover
• Author(s): Y.H. Hui | Merle D. Pierson • Publisher: Taylor & Francis • Publisher Imprint: CRC Press • Subject: Food Science & TechnologyAbout the Book Contains new chapters on the role of U. S. poison centers in bacterial exposures; bac...
View full detailsFood, Morals And Meaning
John Coveney
Paperback
• Author(s): John Coveney • Publisher: Taylor & Francis • Publisher Imprint: Routledge • Subject: Food Science & Technology • BISAC: Ethics & Moral PhilosophyAbout the Book First published in 2006. Food, Morals and Meaning examines ou...
View full detailsFood Science Technology and Nutrition for Babies and Children
Tomy J. Gutiérrez
Paperback
• Author(s): Tomy J. Gutiérrez • Publisher: Springer Verlag • Publisher Imprint: Springer • Subject: Food Science & Technology • BISAC: Food Science - GeneralAbout the Book Infants and children are regularly fed with processed foods, yet desp...
View full detailsFood Frying: Chemistry Biochemistry And Safety
Zeb
Hardcover
• Author(s): Zeb • Publisher: Wiley • Publisher Imprint: Wiley • Subject: Food Science & Technology • BISAC: Food Science - GeneralAbout the Book A wide-ranging exploration of the science and practice of food frying Frying is one of the world...
View full detailsFood Fermentation And Micro-Organisms Second Edition
Bamforth
Hardcover
• Author(s): Bamforth • Publisher: Wiley • Publisher Imprint: Blackwell • Subject: Food Science & Technology • BISAC: Food Science - GeneralAbout the Book Fermentation and the use of micro-organisms is one of the most important aspects of foo...
View full detailsFood and Society: 1ed
Mark Gibson
Paperback
• Author(s): Mark Gibson • Publisher: Elsevier • Publisher Imprint: Acad Pr • Subject: Food Science & Technology • BISAC: Food Science - GeneralAbout the Book Food and Society provides a broad spectrum of information to help readers understan...
View full detailsFood And Drink - Good Manufacturing Practice - A Guide To Its: Responsible Management (Gmp7) 7Th Edition
Manning
Paperback
• Author(s): Manning • Publisher: Wiley • Publisher Imprint: Wiley • Subject: Food Science & Technology • BISAC: Food Science - GeneralAbout the Book The latest updated edition of the market-leading guide to Good Manufacturing Practice (GMP) ...
View full detailsFight Against Food Shortages and Surpluses The
John McClintock
Paperback
• Author(s): John McClintock • Publisher: CABI • Publisher Imprint: CABI Publishing • Subject: Food Science & Technology • BISAC: Industries - AgribusinessAbout the Book This book presents a logical argument, rigorously formulated, for practi...
View full detailsEvolutionary Algorithms for Food Science and Technology
Evelyne Lutton, Nathalie Perrot, Alberto Tonda
Hardcover
• Author(s): Evelyne Lutton | Nathalie Perrot | Alberto Tonda • Publisher: Wiley • Publisher Imprint: Wiley-ISTE • Subject: Food Science & Technology • BISAC: Computer EngineeringAbout the Book Researchers and practitioners in food science an...
View full detailsEssentials of Food Science
Vaclavik, Vickie A.
Paperback
• Author(s): Vaclavik, Vickie A. • Publisher: Springer Verlag • Publisher Imprint: Springer • Subject: Food Science & Technology • BISAC: Food Science - Chemistry & BiotechnologyAbout the Book The fifth edition of this classic text contin...
View full detailsEssential Guide To Food Additives
Victoria Emerton
Paperback
• Author(s): Victoria Emerton • Publisher: Royal Society of Che • Publisher Imprint: RSC • Subject: Food Science & TechnologyAbout the Book Food additives are the cause of a great deal of discussion and suspicion. Now in its third edition, Es...
View full detailsEMERGING NATURAL HYDROCOLLOIDS: RHEOLOGY AND FUNCTIONS
RAZAVI
Hardcover
• Author(s): RAZAVI • Publisher: Wiley • Publisher Imprint: Wiley • Subject: Food Science & Technology • BISAC: Food Science - GeneralAbout the Book Der erste Leitfaden zu den Funktionen, Strukturen und Anwendungen nat�rlicher Hydrokolloide...
View full detailsEcosustainable Polymer Nanomaterials For Food Packaging: Innovative Solutions, Characterization Needs, Safety and Environmental Issues
Clara Silvestre
Hardcover
• Author(s): Clara Silvestre • Publisher: Taylor & Francis • Publisher Imprint: CRC Press • Subject: Food Science & Technology • BISAC: Food Science - GeneralAbout the Book Polymer nanotechnology offers exciting benefits to the food indus...
View full detailsE Is For Eating: An Alphabet of Greed
Tom Parker Bowles, Matthew Rice
Hardcover
• Author(s): Tom Parker Bowles | Matthew Rice • Publisher: Long Barn • Publisher Imprint: Long Barn • Subject: Food Science & Technology
Drying and Storage of Cereal Grains
B. K. Bala
Hardcover
• Author(s): B. K. Bala • Publisher: Wiley • Publisher Imprint: Blackwell • Subject: Food Science & Technology • BISAC: Food Science - GeneralFinite Element Analysis and Computational Fluid Dynamics have been introduced in modelling and simul...
View full detailsDigital Food: From Paddock to Platform
Tania Lewis
Paperback
• Author(s): Tania Lewis • Publisher: Bloomsbury • Publisher Imprint: Bloomsbury Academic • Subject: Food Science & Technology • BISAC: Agriculture & Food (see also Political Science - Public PoliTania Lewis offers the first critical acco...
View full detailsDietary Fibre Functionality in Food & Nutraceuticals: From Plant to Gut
B. Dave Oomah, Rocio Campos-Vega
Hardcover
• Author(s): B. Dave Oomah | Rocio Campos-Vega • Publisher: Wiley • Publisher Imprint: Blackwell • Subject: Food Science & Technology • BISAC: Food Science - GeneralAbout the Book Increasing fiber consumption can address, and even reverse the...
View full detailsDevouring Japan: Global Perspectives on Japanese Culinary Identity
Nancy K. Stalker
Paperback
• Author(s): Nancy K. Stalker • Publisher: Oxford UP • Publisher Imprint: Oxford UP • Subject: Food Science & Technology • BISAC: Asia - JapanAbout the Book In recent years Japan's cuisine, or washoku, has been eclipsing that of France as the...
View full detailsDairy Products
Rhea Ferandes
Hardcover
• Author(s): Rhea Ferandes • Publisher: Leatherhead Food • Publisher Imprint: Leatherhd. • Subject: Food Science & TechnologyAbout the Book Milk and dairy products form a central part of the human diet, as they are rich in nutrients. On the o...
View full detailsChemical Food Safety
Leon Brimer
Paperback
• Author(s): Leon Brimer • Publisher: CABI • Publisher Imprint: CABI • Subject: Food Science & Technology • BISAC: Food Science - GeneralAbout the Book Preventing contamination with problematic chemical compounds in food requires an understan...
View full detailsCarbohydrases From Trichoderma Reesei And Other Microorganisms: Structures, Biochemistry, Genetics and Applications
M. Claeyssens
Hardcover
• Author(s): M. Claeyssens • Publisher: Royal Society of Che • Publisher Imprint: RSC • Subject: Food Science & TechnologyOnce dubbed "the green fungus among us", "trichoderma reesei" has long been at the centre of research into the biochemis...
View full detailsCanning And Preserving For Dummies
Karen Ward
Paperback
• Author(s): Karen Ward • Publisher: Wiley • Publisher Imprint: Wiley • Subject: Food Science & TechnologyAbout the Book Thought about canning and preserving your own food? Maybe you haven't given it a try because you believed it would be too...
View full detailsBiofuels Bioenergy and Food Security: Technology Institutions and Policies 1ed:: Technology, Institutions and Policies
Debnath Deepayan, Suresh Chandra Babu
Paperback
• Author(s): Debnath Deepayan | Suresh Chandra Babu • Publisher: Elsevier • Publisher Imprint: Acad Pr • Subject: Food Science & Technology • BISAC: GeneralAbout the Book Biofuels, Bioenergy and Food Security: Technology, Institutions and Pol...
View full detailsAsian Flavours: Unlock Culinary Secrets with Spices, Sauces & Other Exotic Ingredients
Wendy Sweetser
Hardcover
• Author(s): Wendy Sweetser • Publisher: Apple Press • Publisher Imprint: Apple Pres • Subject: Food Science & TechnologyA melting pot of cultures and eating habits, Asia's cuisines are a reflection of the broad diversity of the peoples who i...
View full detailsAppetizers For Dummies
Dede Wilson
Paperback
• Author(s): Dede Wilson • Publisher: Wiley • Publisher Imprint: Wiley • Subject: Food Science & Technology • BISAC: Courses & Dishes - AppetizersAbout the Book First impressions count, and nothing makes a better first impression on dinne...
View full detailsAmerican Brasserie: 180 Simple, Robust Recipes Inspired by the Rustic Foods of France, Italy and America
Rick Tramonto, Gale Gand
Paperback
• Author(s): Rick Tramonto | Gale Gand • Publisher: Wiley • Publisher Imprint: Wiley • Subject: Food Science & TechnologyAbout the Book Traditional French brasseries serve robust food with maximum flavour and minimum fuss. The authors present...
View full detailsAluminium In Food And The Environment
Robert C. Massey, David Taylor
Hardcover
• Author(s): Robert C. Massey | David Taylor • Publisher: Royal Society of Che • Publisher Imprint: RSC • Subject: Food Science & TechnologyAbout the Book There is currently considerable interest in the possible health risk arising from human...
View full detailsAllergens - Food Chain Allergen Management
Victoria Emerton
Hardcover
• Author(s): Victoria Emerton • Publisher: Royal Society of Che • Publisher Imprint: RSC • Subject: Food Science & Technology • BISAC: Food ScienceAbout the Book This book is the proceedings from a national conference on allergen management. ...
View full detailsAdvances In Food And Nutrition Research (Vol. 57)
Steve Taylor
Hardcover
• Author(s): Steve Taylor • Publisher: Elsevier • Publisher Imprint: Acad Pr • Subject: Food Science & Technology • BISAC: Food Science - GeneralAbout the Book Advances in Food and Nutrition Research recognizes the integral relationship betwe...
View full detailsAdhesion in Foods: Fundamental Principles and Applications
Amos Nussinovitch
Hardcover
• Author(s): Amos Nussinovitch • Publisher: Wiley • Publisher Imprint: Wiley • Subject: Food Science & Technology • BISAC: Food Science - GeneralAbout the Book To the layman, adhesion is a simple matter of how well two different materials sti...
View full detailsA Consumer'S Guide To Gm Food: From Green Genes to Red Herrings
Alan McHughen
Paperback
• Author(s): Alan McHughen • Publisher: Oxford UP • Publisher Imprint: Oxford UP • Subject: Food Science & TechnologyAbout the Book Are you surprised to know that there are fish genes in some tomatoes? That brazil nut genes in soybeans can re...
View full details30-Minute Meals For Dummies
Bev Bennett
Paperback
• Author(s): Bev Bennett • Publisher: Wiley • Publisher Imprint: Wiley • Subject: Food Science & Technology • BISAC: Methods - Quick & EasyAbout the Book Walking into a kitchen that's filled with cooking aromas is a delightful and comfort...
View full details